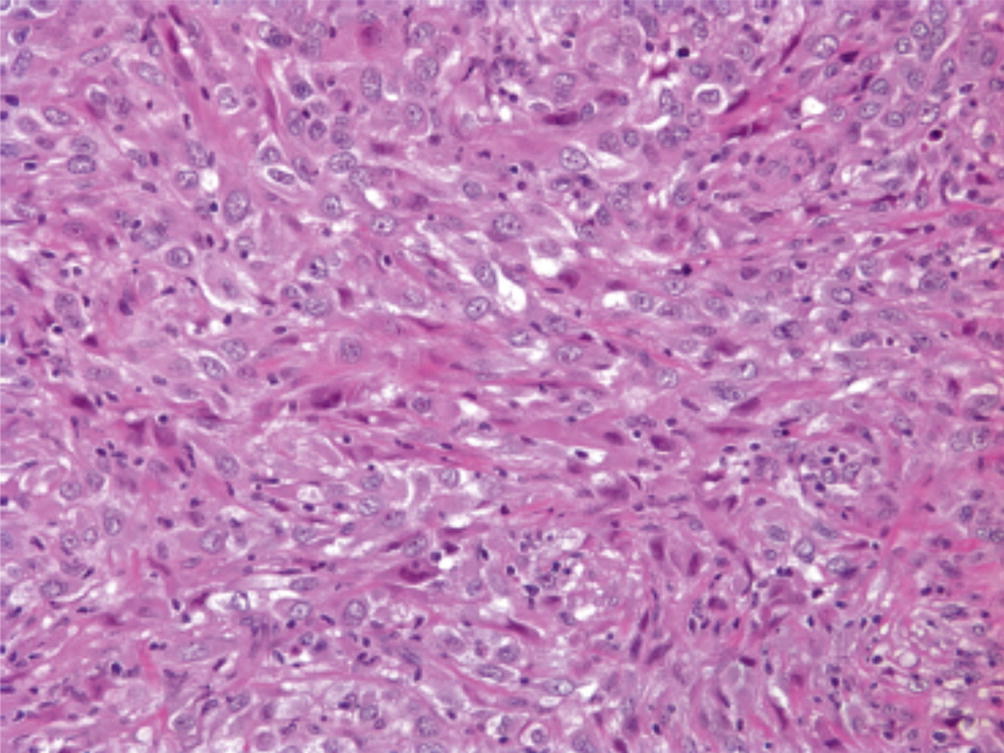

Typically ve in adenocarcinoma. For the 3 histologic subtypes of malignant pleural mesothelioma mpm epithelioid sarcomatoid and biphasic the magnitude of benefit with surgical management remains underdefined.
 Pathology Outlines Mesothelioma Epithelioid
Pathology Outlines Mesothelioma Epithelioid
Pleura mesothelioma biphasic.

Biphasic mesothelioma pathology outlines. Biphasic mesothelioma refers to tumors that contain epithelial and sarcomatoid cells. Should be 50 dense tissue with storiform pattern atypical cells. The biphasic cell type is a mixture of the two other major mesothelioma cell types.
The pathology of tumor growth. Pleura peritoneum diffuse malignant mesothelioma. 10 of epithelioid 10 sarcomatoid.
It is the second most common mesothelioma cell type. Bap1 loss is a useful adjunct to distinguish malignant mesothelioma including the adenomatoid like variant from benign. Biphasic mesothelioma is a combination of epithelioid cells and sarcomatoid cells.
Ihc mesothelioma versus mesothelial. Mesothelioma pathology focuses on understanding how mesothelial cells form spread and interact in the body. Like all other cell types of mesothelioma asbestos exposure is the leading cause of the disease.
Clinical trials are testing new drugs and treatments specifically for mesothelioma patients with biphasic tumors. Biphasic mesothelioma is the second most common of the three major mesothelioma cell types. Up to 30 casesmillion peopleyear in australia great britain.
Taken by histologic type 643 of biphasic 554 of epithelioid and 417 of sarcomatoid mm were bap1 deficient. The cancer must include at least 10 of each cell to be classified as biphasic mesothelioma. Institute of pathology cytology molecular pathology wetzlar.
The national cancer data base was queried for newly diagnosed nonmetastatic mpm with known histology. Observing the anatomy of a particular cancer or how the tumors grow and develop is one way of diagnosing mesothelioma. Life expectancy after diagnosis with biphasic mesothelioma depends upon which cell predominates in the tumor.
Treatment and prognosis depends on which cell type is more prevalent. This website is intended for pathologists and laboratory personnel who understand that medical information is imperfect and must be interpreted using reasonable medical judgment. Pathologists study normal and diseased tissue to make an accurate diagnosissince mesothelioma is often mistaken for other diseases and cancers these cellular studies are vital in properly detecting mesothelioma before it becomes more advanced.
In contrast all 42 ats showed. Mesothelioma pathology provides a full picture of the cancer contributing to a more accurate diagnosis and an informed treatment plan. Strong association with asbestos exposure either occupational eg shipbuilding construction automotive industry or residential industrial contamination environmental domestic br j ind med 196017260 lung cancer 200445s3 incidence varies by geographic location.
 Pathology Outlines Peritoneal Malignant Mesothelioma
Pathology Outlines Peritoneal Malignant Mesothelioma
 Pathology Outlines Mesothelioma Epithelioid
Pathology Outlines Mesothelioma Epithelioid
 Pathology Outlines Mesothelioma Epithelioid
Pathology Outlines Mesothelioma Epithelioid
Pathology Outlines Mesothelioma
 Pathology Outlines Mesothelioma Epithelioid
Pathology Outlines Mesothelioma Epithelioid
 Pathology Outlines Mesothelioma Epithelioid
Pathology Outlines Mesothelioma Epithelioid
 Pathology Outlines Mesothelioma Epithelioid
Pathology Outlines Mesothelioma Epithelioid
Pathology Outlines Diffuse Malignant Mesothelioma
Pathology Outlines Diffuse Malignant Mesothelioma
 Pathology Outlines Peritoneal Malignant Mesothelioma
Pathology Outlines Peritoneal Malignant Mesothelioma
Pathology Outlines Mesothelioma
 Pathology Outlines Mesothelioma Epithelioid
Pathology Outlines Mesothelioma Epithelioid
 Pathology Outlines Mesothelioma Epithelioid
Pathology Outlines Mesothelioma Epithelioid
 Pathology Outlines Diffuse Malignant Mesothelioma
Pathology Outlines Diffuse Malignant Mesothelioma
 Malignant Mesothelioma Libre Pathology
Malignant Mesothelioma Libre Pathology

Pathology Of Mesothelioma Microscopic Features Dr Sampurna Roy Md

Sarcomatoid Mesothelioma Pathology Outlines
Mesothelioma Versus Adenocarcinoma Pathology Outlines Creative Art
 Sarcomatoid Mesothelioma Pathology Outlines
Sarcomatoid Mesothelioma Pathology Outlines
Peritoneal Mesothelioma Pathology Outlines
Pathology Of Mesothelioma Microscopic Features Dr Sampurna Roy Md
Https Encrypted Tbn0 Gstatic Com Images Q Tbn 3aand9gcqeiy6h7ynq0bzuozuqljobr7k9gt0qrqzuqzhy7qweho6z2ryw Usqp Cau
Desmoplastic Mesothelioma Histology
 Localized Malignant Mesothelioma An Unusual And Poorly Characterized Neoplasm Of Serosal Origin Best Current Evidence From The Literature And The International Mesothelioma Panel Modern Pathology
Localized Malignant Mesothelioma An Unusual And Poorly Characterized Neoplasm Of Serosal Origin Best Current Evidence From The Literature And The International Mesothelioma Panel Modern Pathology
 Diagnosis Of Mesothelioma Sciencedirect
Diagnosis Of Mesothelioma Sciencedirect
Malignant Mesothelioma Springerlink
Malignant Mesothelioma Springerlink
Epithelioid Mesothelioma Histology
 Epithelioid Mesothelioma Treatment Symptoms Prognosis
Epithelioid Mesothelioma Treatment Symptoms Prognosis
 Case N 35 Pleural Effusion Mesothelioma Cytology Blog Site
Case N 35 Pleural Effusion Mesothelioma Cytology Blog Site
 Mesothelioma Cell Types Epithelioid Sarcomatoid And Biphasic Cells
Mesothelioma Cell Types Epithelioid Sarcomatoid And Biphasic Cells
 Malignant And Borderline Mesothelial Tumors Of The Pleura Sciencedirect
Malignant And Borderline Mesothelial Tumors Of The Pleura Sciencedirect
Desmoplastic Malignant Mesothelioma Mandulfo37
Guidelines For The Diagnosis And Treatment Of Malignant Pleural Mesothelioma Van Zandwijk Journal Of Thoracic Disease
Guantaldus16 Biphasic Mesothelioma Histology
 Mesothelioma Cell Types Epithelioid Sarcomatoid And Biphasic Cells
Mesothelioma Cell Types Epithelioid Sarcomatoid And Biphasic Cells
Pathology Of Synovial Sarcoma Dr Sampurna Roy Md
 Cd9 Expression As A Favorable Prognostic Marker For Patients With Malignant Mesothelioma
Cd9 Expression As A Favorable Prognostic Marker For Patients With Malignant Mesothelioma
Mesothelioma Versus Adenocarcinoma Pathology Outlines Creative Art
 Sarcomas And Sarcomatoid Neoplasms Of The Lungs And Pleural Surfaces Sciencedirect
Sarcomas And Sarcomatoid Neoplasms Of The Lungs And Pleural Surfaces Sciencedirect
 Outlines Of Reported Cases Of Mpm Invading Liver And Primary Hepatic Download Table
Outlines Of Reported Cases Of Mpm Invading Liver And Primary Hepatic Download Table
 Epithelioid Mesothelioma The Most Treatable Mesothelioma
Epithelioid Mesothelioma The Most Treatable Mesothelioma
 Mesothelioma Cell Types Epithelioid Sarcomatoid And Biphasic Cells
Mesothelioma Cell Types Epithelioid Sarcomatoid And Biphasic Cells
 Pathology Of The Pleura What The Pulmonologists Need To Know Cagle 2011 Respirology Wiley Online Library
Pathology Of The Pleura What The Pulmonologists Need To Know Cagle 2011 Respirology Wiley Online Library
 Figure 3 Primary Malignant Pericardial Mesothelioma Jacc Case Reports
Figure 3 Primary Malignant Pericardial Mesothelioma Jacc Case Reports
Https Encrypted Tbn0 Gstatic Com Images Q Tbn 3aand9gctavdn5rq6ogml6mbrkvulkbg8b Tuympbyippf068sohuie1ny Usqp Cau
 Well Differentiated Papillary Mesothelioma Of The Pleura A The American Journal Of Surgical Pathology
Well Differentiated Papillary Mesothelioma Of The Pleura A The American Journal Of Surgical Pathology
 Metastasis Of Mesothelioma To The Maxillary Gingiva
Metastasis Of Mesothelioma To The Maxillary Gingiva
Http Www Turkjpath Org Pdf Php3 Id 1645
 Malignant Mesothelioma Springerlink
Malignant Mesothelioma Springerlink
Http Www Turkjpath Org Pdf Php3 Id 1645

Https Link Springer Com Content Pdf 10 1007 2f978 3 319 66796 6 14 Pdf
Http Www Turkjpath Org Pdf Php3 Id 1645
 Histopathology Lung Pleura Mesothelioma Youtube
Histopathology Lung Pleura Mesothelioma Youtube
 The 2015 Who Classification Of Tumors Of The Heart And Pericardium Sciencedirect
The 2015 Who Classification Of Tumors Of The Heart And Pericardium Sciencedirect
Https Link Springer Com Content Pdf 10 1007 2f978 3 319 66796 6 14 Pdf
Https Link Springer Com Content Pdf 10 1007 2f978 3 319 66796 6 14 Pdf
 Biphasic Mesothelioma Mesothelioma Cancer
Biphasic Mesothelioma Mesothelioma Cancer
Https Www Jto Org Article S1556 0864 15 33571 1 Pdf
 Diagnosis Of Mesothelioma Sciencedirect
Diagnosis Of Mesothelioma Sciencedirect
 Can You Identify Each Mesothelioma Cell Type Mesothelioma Guide
Can You Identify Each Mesothelioma Cell Type Mesothelioma Guide
Https Link Springer Com Content Pdf 10 1007 2f978 3 319 66796 6 14 Pdf
Latest Govt Job Bank Recruitment Job Vacancy By Rojgarseva
 Histology Erbb Receptor Expression And Survival Analysis Of Patients Download Scientific Diagram
Histology Erbb Receptor Expression And Survival Analysis Of Patients Download Scientific Diagram
 Mesothelioma Pathology Dermnet Nz
Mesothelioma Pathology Dermnet Nz
 Epithelioid Mesothelioma Histology
Epithelioid Mesothelioma Histology
 Mesothelioma Cell Types Epithelioid Sarcomatoid And Biphasic Cells
Mesothelioma Cell Types Epithelioid Sarcomatoid And Biphasic Cells
Https Link Springer Com Content Pdf 10 1007 2f978 3 319 66796 6 14 Pdf
Https Encrypted Tbn0 Gstatic Com Images Q Tbn 3aand9gcsmbbiaydwoksjg3i6aqmhb8eu7 Wuquidxjd63dkvjt9nv5jgr Usqp Cau
 Cancers Free Full Text Immunohistochemistry For Diagnosis Of Metastatic Carcinomas Of Unknown Primary Site Html
Cancers Free Full Text Immunohistochemistry For Diagnosis Of Metastatic Carcinomas Of Unknown Primary Site Html
 Malignant And Borderline Mesothelial Tumors Of The Pleura Sciencedirect
Malignant And Borderline Mesothelial Tumors Of The Pleura Sciencedirect
 Mesothelioma Pathology Dermnet Nz
Mesothelioma Pathology Dermnet Nz
Https Link Springer Com Content Pdf 10 1007 2f978 3 319 66796 6 14 Pdf
 Mesothelioma Cell Types Epithelioid Sarcomatoid And Biphasic Cells
Mesothelioma Cell Types Epithelioid Sarcomatoid And Biphasic Cells
 Neoplasia And The Heart Jacc Journal Of The American College Of Cardiology
Neoplasia And The Heart Jacc Journal Of The American College Of Cardiology
Epithelioid Mesothelioma Pathology Outlines
Pathology Of Mesothelioma Microscopic Features Dr Sampurna Roy Md
Https Onlinelibrary Wiley Com Doi Pdf 10 1111 J 1440 1843 2011 01957 X

 Diagnosis Of Mesothelioma Sciencedirect
Diagnosis Of Mesothelioma Sciencedirect
 Cancers Free Full Text Immunohistochemistry For Diagnosis Of Metastatic Carcinomas Of Unknown Primary Site Html
Cancers Free Full Text Immunohistochemistry For Diagnosis Of Metastatic Carcinomas Of Unknown Primary Site Html
 Pdf Cd90 Is A Diagnostic Marker To Differentiate Between Malignant Pleural Mesothelioma And Lung Carcinoma With Immunohistochemistry
Pdf Cd90 Is A Diagnostic Marker To Differentiate Between Malignant Pleural Mesothelioma And Lung Carcinoma With Immunohistochemistry
 Pleural Mesothelioma Histology
Pleural Mesothelioma Histology
 Mesothelioma Cytology Malignant Cancer Diagnosis By Fluid Sample
Mesothelioma Cytology Malignant Cancer Diagnosis By Fluid Sample
 Malignant And Borderline Mesothelial Tumors Of The Pleura Sciencedirect
Malignant And Borderline Mesothelial Tumors Of The Pleura Sciencedirect
 Soft Tissue Tumors Chapter 9 Silverberg S Principles And Practice Of Surgical Pathology And Cytopathology
Soft Tissue Tumors Chapter 9 Silverberg S Principles And Practice Of Surgical Pathology And Cytopathology
Https Link Springer Com Content Pdf 10 1007 2f978 3 319 66796 6 14 Pdf
 Outlines In Pathology John H Sinard Md Phd
Outlines In Pathology John H Sinard Md Phd
 Immunohistochemistry Of Soft Tissue Tumours Review With Emphasis On 10 Markers Miettinen 2014 Histopathology Wiley Online Library
Immunohistochemistry Of Soft Tissue Tumours Review With Emphasis On 10 Markers Miettinen 2014 Histopathology Wiley Online Library
Https Encrypted Tbn0 Gstatic Com Images Q Tbn 3aand9gcqhndw3xybl10o6yw8h23fyy2skbzdzyzvpcqqbh7zwpgmcakti Usqp Cau
 Mesothelioma Help Cancer Organization
Mesothelioma Help Cancer Organization
 Frontiers Why Be One Protein When You Can Affect Many The Multiple Roles Of Yb 1 In Lung Cancer And Mesothelioma Cell And Developmental Biology
Frontiers Why Be One Protein When You Can Affect Many The Multiple Roles Of Yb 1 In Lung Cancer And Mesothelioma Cell And Developmental Biology
Https Www Jto Org Article S1556 0864 20 30174 X Pdf
 Mesothelioma Pathology Dermnet Nz
Mesothelioma Pathology Dermnet Nz









0 komentar:
Posting Komentar